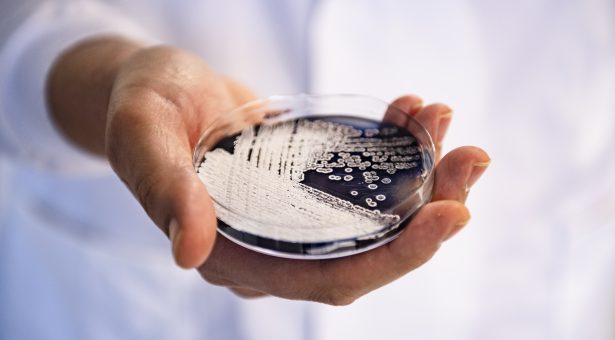

How, and why, do plants and microbes interact?
Microbes are found almost everywhere on Earth, and have evolved over the past 3.5 billion years to survive and thrive in diverse habitats, including in and on plants. Microbes are organisms that are too small to be seen without using a microscope, so they include things like bacteria and single cell eukaryotes — cells that have a nucleus, like an amoeba or a paramecium.
To plants, some microbes are beneficial, whilst others can cause devastating diseases. The relationship between plants and microbes is complex and has persisted since their evolution.
The two communities interact in various ways including by exchanging nutrients, providing defence responses, recognition and attachment, and through symbiotic association. Understanding the mechanisms of these interactions is essential to tackle global challenges like disease resistance, food security, and climate change.
Nutrient exchange and microbial recruitment
Beneficial relationships between plants and microbes often begin with photosynthesis, where sugars are produced to serve as a type of exchange currency with microbes.
Plants may struggle to access certain nutrients in the soil by themselves and therefore release these sugars and other compounds in exchange for the microbes providing essential elements like nitrogen and phosphorus.
This steering of microbial behaviour is mainly focused to three zones of the plant: the rhizosphere (around the roots), the endosphere (within internal compartments), and the phyllosphere (parts of the plant found above the ground).
Interactions with beneficial microbes in these zones provide several useful services, such as stimulation of growth, and plants have developed unique ways of recruiting specific microbes with attributes which will help that type of plant thrive best.
For example, a 2024 JIC study by Professor Jacob Malone demonstrated how barley can fine-tune its root microbial communities by releasing a custom mix of sugars and other compounds. By analysing the microbiomes from two types of barley – Tipple and Chevallier – the study showed that the two types each had an overlapping core group of microbes associated with their roots, but with some distinct differences in the overall communities. When researchers swapped the microbial communities between the two types, the barley varieties didn’t grow as well as they were able to when exposed to their original community.
By producing compounds that help plants tolerate environmental stresses (such as drought, salinity, and temperature extremes), microbes can enable them to thrive in diverse environments where they would typically struggle.
Defence mechanisms
Some bacteria and fungi act as natural bodyguards, for example rhizobacteria and mycorrhizal fungi. The role of these helpful bacteria and fungi is to act as natural defenders, forming a protective shield around plant surfaces. This defence mechanism extends beyond an individual plant, contributing to the resilience of the entire ecosystem.
One example of this is how Pseudomonas bacteria have been shown to produce small molecules that can have an antibacterial effect on the pathogenic bacteria that cause potato scab, a disease which causes major losses to potato harvests.
In agriculture, certain strains of helpful microbes can even be applied to crops to suppress the growth of pathogens.
By understanding and harnessing the beneficial interactions between plants and microbes, new strategies to prevent plant diseases and increase productivity can be developed.
Pathogenic interactions
Despite the benefits that microbes can provide, interactions between plants and microbes can dramatically change, progressing from a beneficial to a pathogenic state.
This can happen for several reasons such as shifts in environmental conditions, plant stress levels, the composition of microbial communities, and/or other genetic factors.
These shifts can introduce opportunities for formerly beneficial microbes to exploit vulnerabilities in plant defence and cause disease.
Plants can recognise pathogenic microbes and initiate mechanisms to trigger immune responses by monitoring microbe-associated molecular patterns (MAMPs). They identify the MAMPs as ‘self’ or ‘foreign’ and can induce an immune response according to this information. This allows plants to reduce infection by pathogenic microbes, without inhibiting beneficial interactions.
The importance of understanding
By understanding and leveraging knowledge of the ways in which plants and microbes communicate and interact, John Innes Centre researchers and our collaborators are at the forefront of designing and genetically constructing plant-microbe communities to improve ecosystems, ensure sustainable agriculture, and combat global issues such as food security in the many years to come.
Find out more about how Norwich Research Park is consolidating and enhancing our microbial research with the new Centre for Microbial Interactions.
With thanks to Keni Duguma, MSc Engineering for Biomedicine student at Imperial College London, who worked on this blog while interning with us, Harshanie Dasanayaka, Postgraduate Research Student, who worked on this blog during her Professional Internships for PhD Students (PIPS) placement, and Sam Rowe, Project Manager at the Centre for Microbial Interactions.



